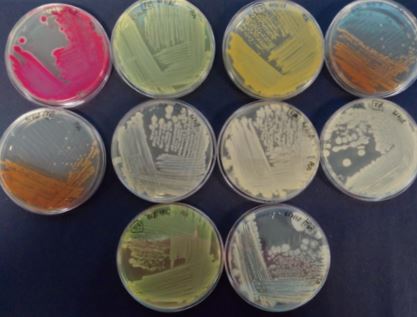

RETEMA, Revista Técnica de Medio Ambiente, ha publicado en su última edición (Marzo-Abril 2023) un reportaje donde comenta los avances en innovación e inversión llevados a cabo en el Centro Integral de Tratamiento de Residuos Montemarta Cónica.
A continuación, se presenta el artículo mencionado.

Aborgase, empresa titular del Centro Montemarta Cónica, y el grupo de empresas que colaboran es su explotación, prestan servicio de tratamiento de residuos sólidos urbanos a Sevilla y su área metropolitana gestionando más de 650.000 toneladas. Aborgase persigue en su actividad un modelo de gestión sostenible, integrando la triple visión de gobernanza, medio ambiente y social, alineando sus objetivos empresariales con los Objetivos de Desarrollo Sostenible.
Sin duda, la sostenibilidad medioambiental juega un papel central en la visión de Aborgase de su negocio.
En esta línea, y siendo la actividad la gestión de residuos, surge la economía circular como concepto fundamental, tanto por hacer la actividad de la gestión de residuos lo más circular posible, como por aprovechar y capitalizar las oportunidades que aparecen en los negocios circulares. De ahí, se establece como principal objetivo estratégico de la compañía la inversión e innovación circular.
La sostenibilidad medioambiental juega un papel central en la visión de Aborgase. De ahí, se establece como principal objetivo estratégico de la compañía la inversión e innovación circular.
A partir de un riguroso análisis del estado de las diferentes tecnologías, se han identificado cuatro áreas de trabajo, categorizadas por fracciones de los residuos en las que trabajar, biogás, materia orgánica, plásticos y rechazos; y estadíos de madurez tecnológico. De esta forma surge un mapa estratégico de oportunidades, para iniciativas de inversión, mejora, innovación o investigación y desarrollo. A continuación, se exponen los proyectos de investigación y desarrollo que se han llevado a cabo o en los que se está trabajando, en las diferentes áreas de trabajo. Estos proyectos son liderados por la empresa del grupo especializada en cada área de negocio, se ejecutan en colaboración con Universidades y Centros de Investigación, y tienen en su fase final una demostración en el Centro Montemarta Cónica, de forma que se valida la tecnología desarrollada, y se favorece la transferencia de tecnología.

- Valorización de Biogás
Esta línea es liderada por Energía Sur de Europa (ENERSUR), actualmente produce electricidad a partir de biogás de vertedero pero la dificultad para su almacenamiento ha llevado a innovar en los usos y valorización del biogás de vertedero para la producción de biometano, reformado de biogás para la producción descentralizada de hidrógeno, conversión de metano en otras moléculas de alto valor añadido mediante procesos catalíticos y la conversión del dióxido de carbono del biogás a metano, tecnología denominada “Power to gas”. En los proyectos específicos para desarrollar tecnologías se colaborando con la Asociación de Investigación y Cooperación Industrial de Andalucía (AICIA) y La Unidad de Valorización Termoquímica Sostenible del Centro de Investigaciones Energéticas, Medioambientales y Tecnológicas (CIEMAT). El primer proyecto desarrollado ha sido el proyecto “Producción descentralizada de hidrógeno a partir de biogás de vertedero (LFG2H2)” o “Landfill gas to Hydrogen” el objetivo era desarrollar un nuevo proceso para la obtención de hidrógeno descentralizado mediante el reformado mixto de biogás de vertedero. En el proyecto se ha conseguido operar un catalizador más de 3.000 horas en continúo produciendo hidrógeno renovable a partir de biogás de vertedero. Por este proyecto ENERSUR, fue galardonada por parte de Shell España con el Premio a la innovación en cogeneración, dentro del XVIII Congreso Anual de Cogeneración organizado por COGEN España y ACOGEN.
Este proyecto ha sido subvencionado por el CDTI en la convocatoria de I+D+i, cofinanciado por el Fondo Europeo de Desarrollo Regional (FEDER). En esta línea se continúa trabajando con la producción de hidrocarburos mediante síntesis de Fischer-Tropsch a partir de biogás de vertedero con el proyecto “Producción de biocombustibles para aviación y productos químicos intermedios mediante síntesis de Fischer-Tropsch a partir de biogás de vertedero” (LFG2JET).
El proyecto permitirá dotarnos de una nueva fuente de energía renovable, sostenible con el desarrollo de un procesador compacto cuyo diseño se llevará a cabo en esta primera fase. Este prototipo se desarrollará para que se pueda instalar en vertederos u otras instalaciones donde se produzca biogás. Esto hará posible la generación de una nueva fuente de ingresos para las instalaciones y la utilización de un recurso renovable.
Este proyecto ha sido subvencionado por el CDTI en la convocatoria de I+D+i, cofinanciado por el Fondo Europeo de Desarrollo Regional (FEDER) y ha contado con un incentivo otorgado por CTA.

- Valorización de la fracción orgánica de los residuos, Biorresiduos
GSA Servicios Ambientales (GSA) lidera esta línea donde actualmente los biorresiduos se someten principalmente a un proceso compostaje que permite producir compost para su uso agrícola. También, podrían ser sometidos a un proceso de digestión anaerobia para producir biogás y biofertilizantes a partir del digestato. Las áreas donde más innovación se puede llevar a cabo es la producción de bioproductos como pueden ser el bioetileno, alcoholes, polihidroxialcanoatos (PHA), ácidos grasos volátiles, biofertilizantes, bioestimulantes… aplicando el concepto de biorrefinería.
GSA realiza la producción y comercialización de material bioestabilizado y tratamiento de residuos orgánicos. Como expansión de esta actividad, surge la iniciativa para desarrollar tecnologías biológicas para obtener productos de alto valor añadido y aplicación agrícola. El desarrollo de proyectos se colabora con centros de investigación como el Instituto Tecnológico del Embalaje, Transporte y Logística (ITENE) y el Instituto de Recursos Naturales y Agrobiología de Sevilla (IRNAS) del CSIC.
El primer proyecto desarrollado ha sido “Investigación y Desarrollo de un nuevo modelo de economía circular para la producción de biofertilizantes a partir de residuos orgánicos (FORSU)” o “Circular Biofertilizers” (C-Biofert).
Los resultados del proyecto han sido el desarrollo de un nuevo proceso de tratamiento y valorización de la fracción orgánica de los residuos sólidos urbanos (FORSU) recogidos selectivamente, identificando microorganismos de interés agrícola con propiedades PGPR (Plant Growth Promoting Rhizobacteria) que han sido capaces de desarrollarse en medio de cultivo procedentes de FORSU, sustituyendo 100% el medio de cultivo comercial y validando su efectividad promotora con ensayos de campo.
Esta área se ha continuado trabajando con el proyecto CompoRISE “Desarrollo e investigación del proceso de bioaumentación para la producción de compost ad hoc basado en microorganismos bioestimulantes y biofertilizantes avanzados” para la generación de biofertilizantes de altas prestaciones a partir de residuos orgánicos.

- Reciclaje mecánico y químico de plásticos
Esta línea es liderada por EDIFESA, el tratamiento principal desarrollado para este tipo de residuos es la valorización mediante la incineración y el reciclaje mecánico de plásticos, pero este último tratamiento se utiliza principalmente para las fracciones rígidas de los plásticos. Los principales puntos para innovar pasan por el desarrollo de tratamiento químico para recuperar los monómeros de partidas utilizados en la síntesis de los plásticos reduciendo el consumo de recursos naturales, entre los tratamientos están principalmente la despolimerización térmica, purificación basada en solventes y la despolimerización química. Es en esta línea donde se enfoca el proyecto “Reciclado y revaloración mediante procesos químicos y mecánicos de la fracción plástico film”, proyecto (FILMVALUE). El objetivo del es dar respuesta a la necesidad de mejorar el reciclaje de los materiales plásticos post-consumo, y en particular de la fracción de plástico film (monocapa y multicapa), ya que ésta es la que tiene actualmente menor grado de reciclaje y revalorización y, por consiguiente, la que genera un mayor impacto medioambiental y tiene una mayor incidencia en la huella de carbono del ciclo de vida de los materiales plásticos. Los trabajos se desarrollan en el centro EDIFESA cuenta con el apoyo del propio Centro Montemarta Cónica, en el que se desarrolla el trabajo, y Andaltec, Centro de innovación y tecnología referencia de la tecnología del plástico. Este proyecto proporciona una solución innovadora que permita reciclar de forma individual plástico film monocapa y multicapa, en componentes plásticos singulares aumentando su tasa recuperación, reduciendo la cantidad que acaba valorizándose energéticamente o enterrada en vertederos.
- Valorización de los rechazos de RSU
La valorización energética de los rechazos generados en las plantas de tratamiento de RSU hoy por hoy se lleva cabo en incineradoras produciendo energía eléctrica “WtE o Waste to Energy” siendo las tecnologías termoquímicas comerciales (pirolisis/ gasificación). En este punto el I+D e innovación pasa por generar moléculas de alto valor añadido en la pirolisis mediante el uso de catalizadores o bien por su síntesis de a partir de gases generados en la gasificación.
En conclusión, con la puesta en marcha de estas iniciativas, el Centro Montemarta Cónica se ha posicionado con una referencia en la implantación de nuevas tecnologías en la gestión de residuos, contribuyendo a un modelo de gestión más circular.

El Centro Montemarta Cónica se ha posicionado como una referencia en la implantación de nuevas tecnologías en la gestión de residuos.
